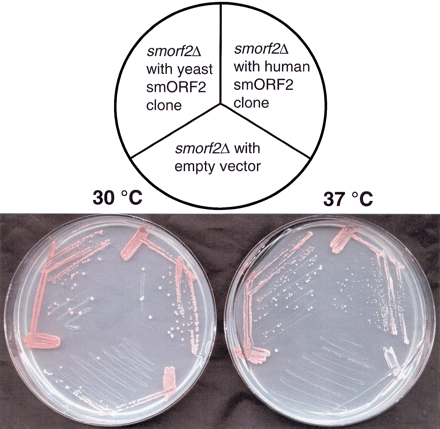
Figure 5.

Figure 5.
Human smORF2 complementation of the temperature-sensitive phenotype of the smorf2Δ strain. A yeast strain with a deleted smORF2 (smorf2Δ) was transformed with plasmids carrying the wild-type yeast smORF2, human smORF2 under the control of the GAL1 promoter, or empty vector. Transformants were obtained at 30°C, and individual colonies were streaked and then incubated at 30°C and 37°C.











